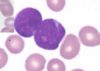
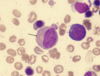
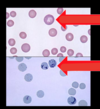
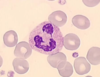
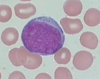
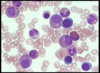
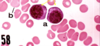
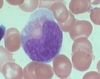
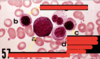
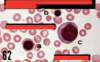

L9 Bone Marrow Flashcards
(45 cards)
ID the cell

Proerythroblast

ID the cell

Metamyelocyte

ID the cells
Lymphoblasts
ID the cell

Band neutrophil
ID cells a, b, e, & f

a. promyelocyte
b. neutrophilic myelocyte
e. neutrophilic band cell
f. segmented neutrophil
ID the cell

promyelocyte

ID the cell

monocyte
ID the cell
metamyelocyte
Identify the smear.
Identify the stain.

Bone marrow aspirate.
Giemsa or Wright stain.
Outline the stages of erythropoiesis shown here.
- myeloid precursor
- proerythroblast (aka pronormoblast)
- basophilic erythroblast/normoblast
- polychromatic erythroblast/normoblast
- orthochromatic erythroblast/normoblast
- reticulocyte (aka polychromatic erythrocyte)
- erythrocyte
ID the cell

Reticulocyte

ID the cell

Polychromatic erythroblast

I cells b, c, d, e, & g

b. neutrophilic metamyelocyte
c. band neutrophil
d. segmented neutrophil
e. segmented neutrophil
g. neutrophilic metamyelocyte
Name the cell indicated by the red arrow #1
Name the cell indicated by the red arrow #2
Name the stain used in the top image.
Name the stain used in the bottom image.
Both are polychromatic erythrocytes.
Top half: Giemsa/Wright stain
Bottom half: supravital stain (new methylene blue or cresyl violet)
Identify the whole tissue.
- Identify structure labeled with the star *

Tissue: Bone Marrow
* = bony trabeculae
Name cells a & b

a. basophilic erythroblast
b. polychromatic erythroblast
ID the cell
Segmented neutrophil
ID the cell
myeloblast
ID the cell

monocyte
ID the cell

Band cell (neutrophil)

Name the stages of development shown here.

- proerythroblast (aka pronormoblast)
- basophilic erythroblast/normoblast
- polychromatic erythroblast/normoblast
- orthochromatic erythroblast/normoblast
- reticulocyte (aka polychromatic erythrocyte)
- erythrocyte

Give the M:E ratio of the following images.
1: 3 = erythroid hyperplasia
11: 4 = myeloid hyperplasia
3: 1 would be normal
Name the cells ‘a’.
These cells will have lots of ______.
Basophilic erythroblasts; ribosomes (for synthesizing heme)
ID the cell

Myelocyte